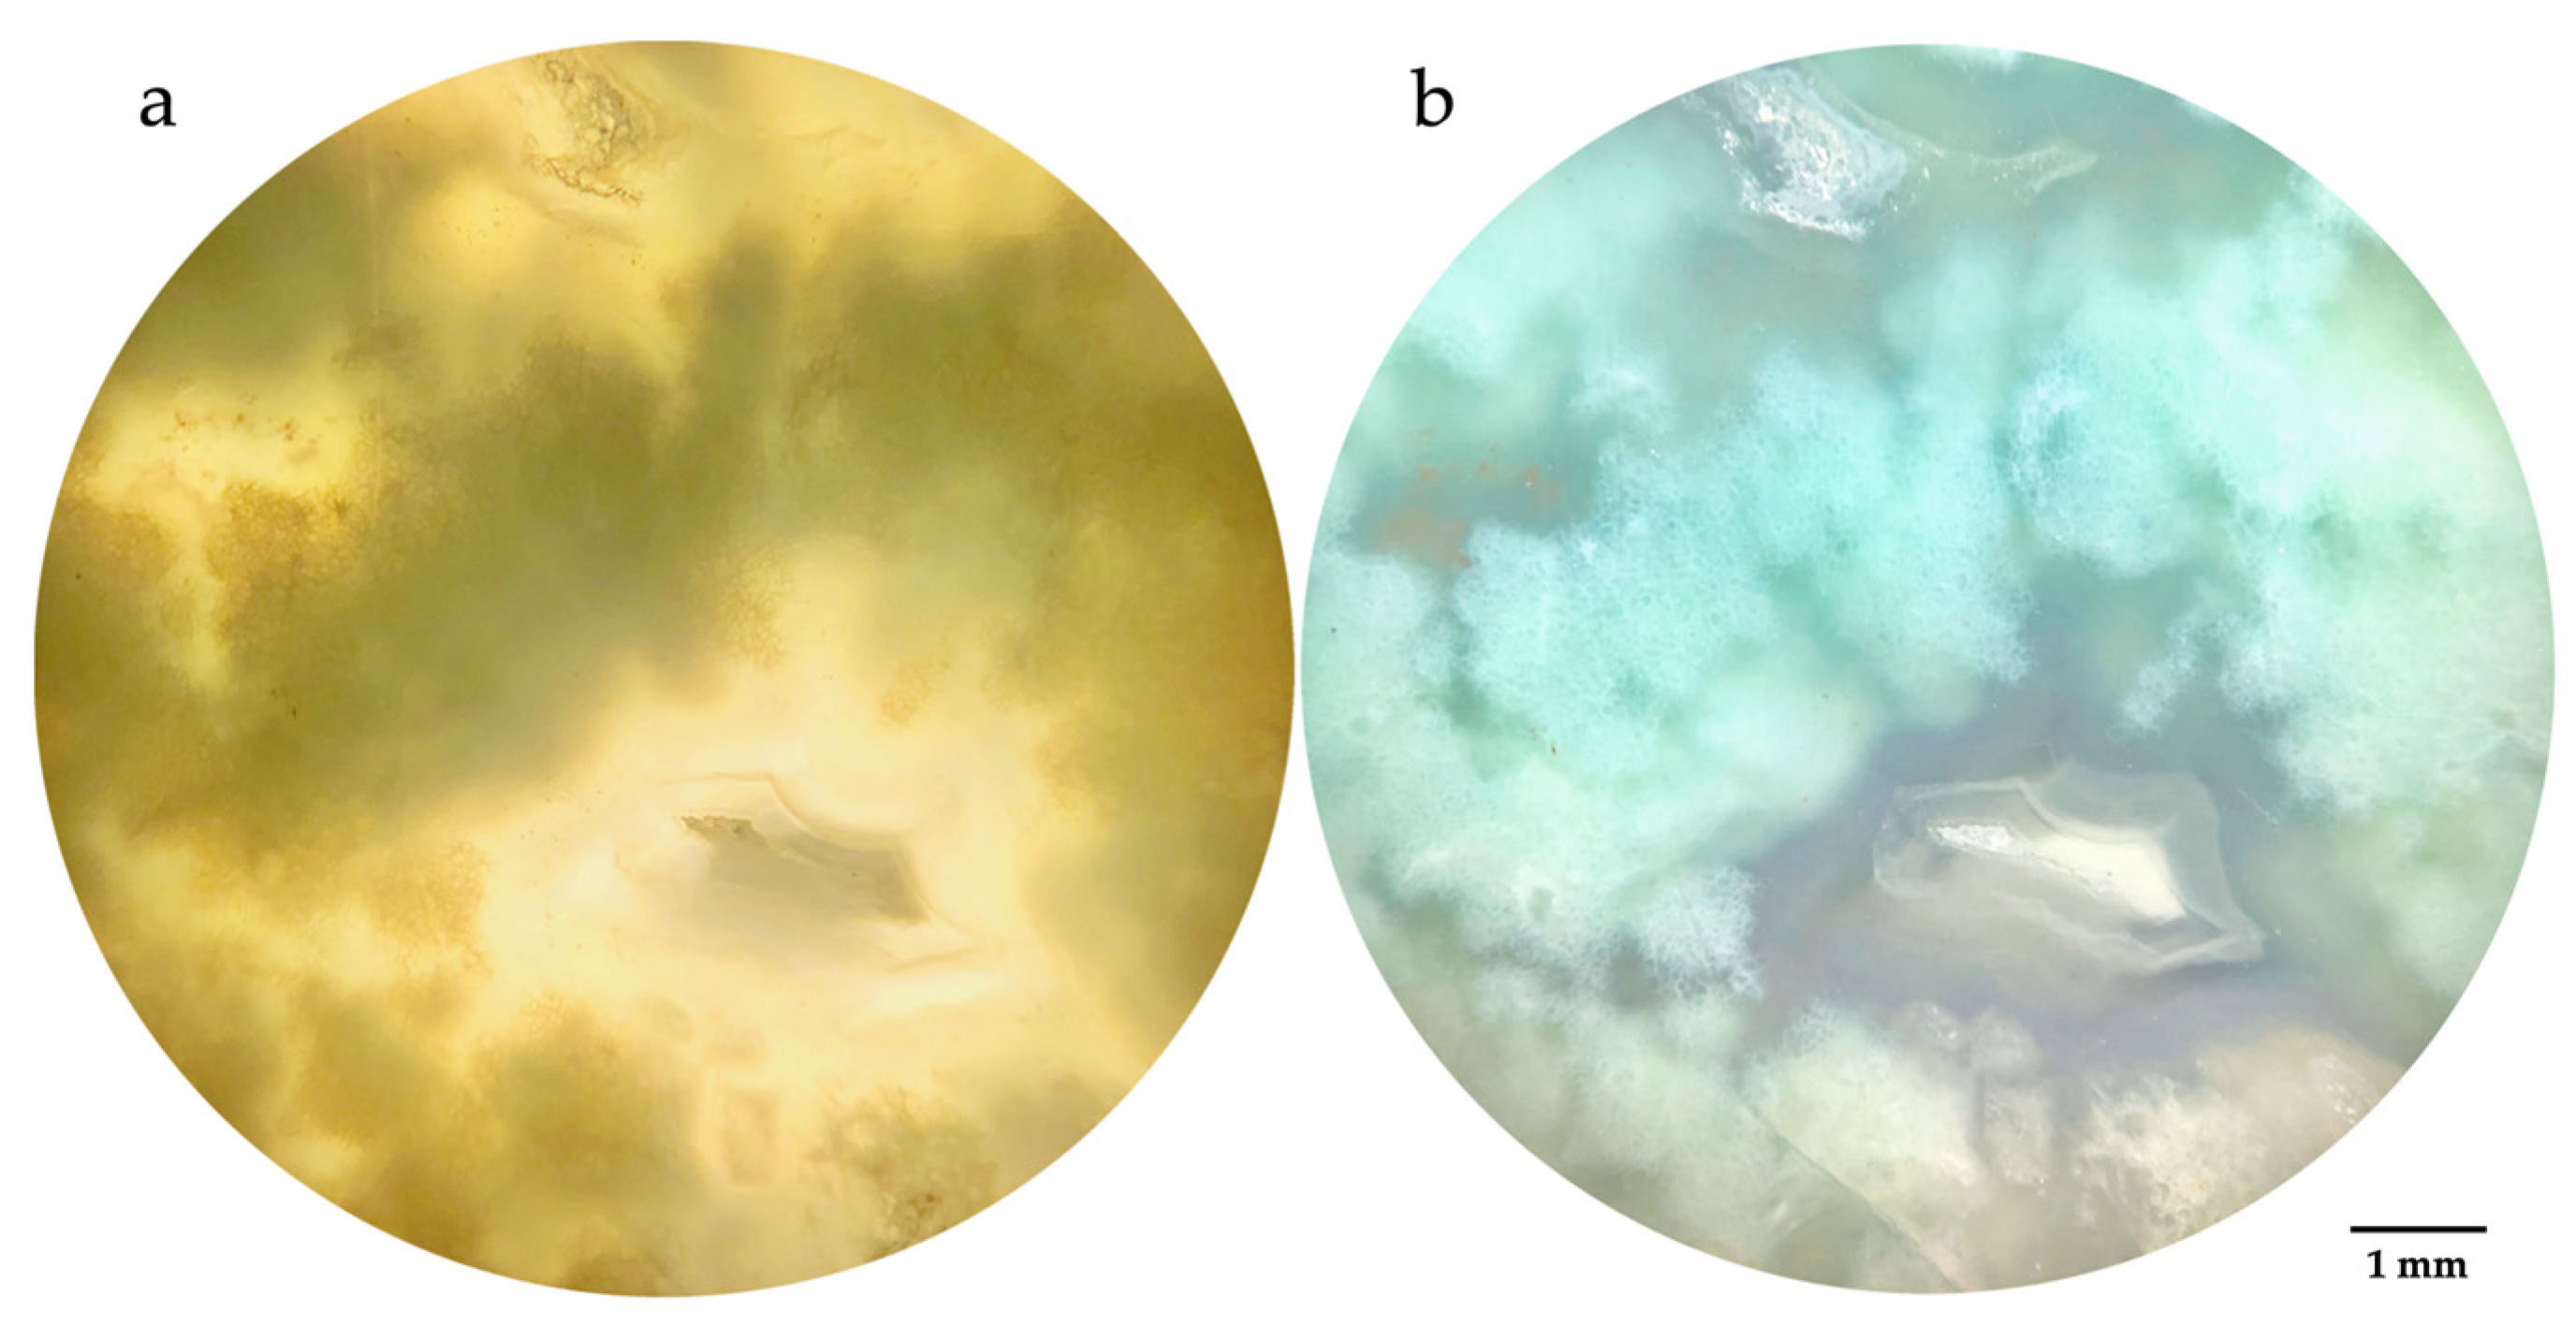
Crystals 14 01003 g002

1. Introduction
Chalcedony is a naturally micro or crypto polycrystalline form of silica that occurs in different varieties, patterns, and colors. Some of the most well-known varieties of chalcedony include (1) carnelian, the orange-red chalcedony, (2) heliotrope or bloodstone, which is characterized by a dark green color with red spots, (3) agate which consists predominantly of concentrically colored banded, and (4) onyx, a distinct variety of agate characterized by black and white bands [
1,
2,
3].
One of the most sought-after chalcedony varieties is the green one, with chrysoprase being highly prized for its appealing apple-green color, which can be attributed to tiny inclusions of nickel-bearing minerals [
2,
4,
5]. The exact nature of these nickel compounds has been debated, with studies suggesting they could be oxides (bunsenite, NiO [
6,
7], or carbonates (gaspeite, (Ni, Fe, Mg)CO
3 [
8]). However, recent research has shown that the green color is due to Ni-bearing phyllosilicates, particularly willemseite (Ni
3Si
4O
10(OH)
2) [
9,
10,
11]. Other studies have proposed the occurrence of pimelite (the discredited IMA-disordered and hydrated equivalent of willemseite) [
12,
13,
14] or Ni-bearing kerolite, part of the “kerolite–pimelite” series [
12,
15].
Chrysoprase has been used as a gemstone since ancient times, with major sources in Queensland and Western Australia, Haneti Hill (Tanzania), Goiás (Brazil), Kazakhstan, Madagascar, Lower Silesia (Poland), Russia, and the United States [
5,
13,
16].
Another variety of green chalcedony is chromium-bearing chalcedony, distinguished by its emerald to dark green color due to the presence of chromium rather than nickel [
2,
5,
17,
18,
19,
20]. Chromium-bearing chalcedony is primarily found in Zimbabwe (near Mtoroshanga), Bolivia (known as “chiquitanite”), and Australia [
5,
17,
18,
20].
A highly valued green-to-blue variety of chalcedony is commonly marketed as gem silica or chrysocolla chalcedony, colored by minute inclusions of chrysocolla, a copper-bearing silicate ([
21], and references therein). Major sources of chrysocolla chalcedony include Taiwan, Peru, the USA, Mexico, Indonesia, and Spain [
21,
22,
23].
In December 2012, gem explorer Yianni Melas discovered a new bluish green chalcedony in Africa, now commercially known as “aquaprase” [
24]. Aquaprase™ is considered the first new gemstone discovery of the 21st century and is trademarked for distribution (
https://www.aquaprase.com URL accessed on 28 October 2024 [
25]). According to one of the authors (YM), the stones appear in the following two different “types”: “aquaprase type 1”, the more common and widespread, as well as transparent with a typical bluish green color, and “aquaprase type 2”, a rarer, less transparent variety with a blue, turquoise-like color. Rarely, a very limited number of samples with an “emerald” dark green color are also found. In the past, aquaprase was misidentified as chrysoprase due to their similar appearance, but a report [
24] showed that its bluish green color is caused by different elements, which are likely chromium and nickel. Recently, an investigation of selected chalcedony varieties, including aquaprase, with a particular focus on structural aspects has been performed [
11].
Aquaprase, due to its rarity and unique characteristics, is positioned at a higher price range compared to common chalcedony and its market value is often higher compared to common chalcedony. As mentioned before, aquaprase was often mistakenly classified as chrysoprase but also, at present, as Cu-chalcedony because its detailed characterization is still missing even though it is essential.
In this light, this research aims to address this gap by analyzing several gem-quality aquaprase samples to achieve a detailed gemological, mineralogical, and microstructural characterization of this bluish green chalcedony. In particular, the sample mineralogy was examined using Raman spectroscopy and XRD, while chemical composition, spanning major to trace elements, was determined via SEM and LA–ICP–MS analysis. Microstructural features were characterized through imaging with optical and scanning electron microscopy.
All these features would not only enhance the precision of gem identification but also facilitate the development of optimized methods for treatment and preservation. Furthermore, a thorough understanding of aquaprase’s unique features could assist the gemological industry in safeguarding against imitations and falsifications, ensuring product authenticity for consumers.
2. Materials and Methods
A total of 15 aquaprase samples from Africa were investigated for the present study (
Figure 1).
The exact geographical and geological locations of the aquaprase deposit are kept confidential to protect the mining sites and preserve the integrity of the deposits. This gemstone is known for its distinctive color and unique inclusions, which set it apart from other varieties of chalcedony.
The samples consisted of 12 polished cabochon-cut gemstones (from 5.15 ct to 21.63 ct) and 3 rough stones (from 20.72 ct to 46.78 ct), with dimensions varying from 19.99 × 34.8 × 10.24 to 22.10 × 43.10 × 7.86 mm.
The samples under analysis were divided into two different categories, specifically based on their color. We will refer to them as “aquaprase type I” (AQ_type I), characterized by a bluish green color, and “aquaprase type II” (AQ_type II), exhibiting a blue “turquoise” color and a cloud-like appearance. In the text, however, we will use the term “aquaprase” as a general reference to the gemological variety of chalcedony.
The refractive indices were measured with a Krüss refractometer (A. Krüss Optronic, Hamburg, Germany) using an ordinary light source with a sodium filter (589 nm) and methylene iodide as a contact liquid (R.I. = 1.80). A Mettler hydrostatic balance was used to determine the specific gravity of the stones, whereas the ultraviolet fluorescence was investigated with a short (254 nm) and long (366 nm) wavelength ultraviolet Analytic Jena Wood lamp (Analytik Jena—Jena, Germany). A Motic GM168 dark-field gemological microscope was used for the microscopic observations of the samples.
Thin sections were observed using a Leitz petrographic microscope (Leitz, Wetzlar, Germany), using magnifications 2.5, 8, and 10× connected to a 51 MP camera.
X-ray diffraction (XRD) measurements were carried out by means of Malvern Panalytical X’Pert-PROMPD X’Celerator diffractometer (Malvern Panalytical, Malvern, UK), using CuKα radiation, at a beam voltage of 40 kV and a current of 40 mA. A step scan of 0.01° 2θ was performed over the range 5–80° 2θ.
Raman spectra were collected by means of a Horiba LabRam HR Evolution System (High-resolution confocal micro Raman system) (Horiba, Ltd., Kyoto, Japan), with a green Nd-YAG laser source (with a wavelength of 532 nm and power of 100 mW), with very low frequency filters (ULF) and a 1 μm spot. The analysis points on thin sections were selected using an Olympus petrographic microscope equipped with the Raman instrument.
Backscattered electron (BSE) images were obtained with a scanning electron microscope. The instrumentation consisted of a JSM-IT500 microscope (Jeol (ITALIA) S.p.A., Milan, Italy), with a tungsten filament source, coupled with an energy dispersive X-ray spectrometer (EDS) IXRF-2000 (0–20 keV).
Laser-ablation–inductively coupled plasma–mass spectroscopy (LA–ICP–MS) measurements were performed using an instrument which couples a Teledyne Analite Excite Excimer laser (air cooler excimer laser with 193 nm ultra-short pulse) (Teledyne Technologies, Inc., Thousand Oaks, CA, USA) to a Thermo Scientific ICP–MS iCAP RQ single quadrupole with a laser spot of 65 μm (Thermo Fisher Scientific, Waltham, MA, USA).
3. Results and Discussions
3.1. Color Analysis
When observed under reflected light, the aquaprase samples displayed a color range from light blue, greenish blue, and bluish green to green, which shifted towards a yellow-green hue when viewed under transmitted light. This “color shift”, particularly prominent in the “turquoise”-like aquaprase type II samples (
Figure 2), is a well-documented phenomenon in chalcedony [
26]. The color perception is influenced by two main factors: (1) selective light absorption through various processes, and (2) light scattering. Specifically, Rayleigh scattering occurs when the scattering centers, which are smaller than the wavelength of visible light and are irregularly distributed, leading to more efficient scattering of high-energy violet and blue wavelengths [
26]. As a result, blue scattered light is visible when the stones are illuminated from above, a characteristic seen in some aquaprase samples. This bluish hue caused by light scattering on microdefects has been previously reported in chalcedony [
12].
3.2. Gemological Analysis
The gemological properties of the 12 polished and the 3 rough aquaprase chalcedony samples are reported in
Table 1. The samples investigated here were semi-transparent to translucent. The refractive index measured by the distant vision method ranged from 1.53 to 1.54, and the specific gravity was between 2.51 and 2.58. These features are consistent with data reported in the literature on cryptocrystalline quartz minerals [
1,
4] and with the data reported for aquaprase chalcedony [
24,
25].
Regarding the UV fluorescence, all the samples showed a moderate bright green to yellowish green reaction to short-wave UV radiation, mostly patchy and zoned, and always only in correspondence to the white areas. A bright green luminescence in short wavelength radiation has already been reported in some microcrystalline and non-crystalline silica gems, such as chalcedony and opal, and it is attributed to the uranyl ion, which is a very effective luminescence activator [
27,
28]. This agrees with the presence of uranium in the trace element composition of the samples (see the section below).
Microscopic examination showed cloudy or patchy whitish and brown areas and banding in some samples (
Figure 3). In a few samples, we observed that the blue color was concentrated in “clouds” dispersed in a white matrix (
Figure 2).
Regarding the distribution of color, some gems showed a homogeneous color, whereas many others displayed color zoning and banding, with white and reddish brown to brown bands and spots often present. Moreover, in some aquaprase type II samples, many blue “clouds” were clearly visible (
Figure 2).
3.3. Mineralogical Analysis
The typical silica phases occurring in chalcedony are α-quartz, the most relevant mineralogical phase, and moganite, a polymorph of silica which is usually intergrown with quartz in chalcedony [
29,
30]. Moganite has a monoclinic symmetry, instead of the trigonal symmetry of α-quartz, and its structure consists of alternating (101) layers of right- and left-handed α-quartz, twinned periodically at the unit-cell scale according to the Brazil-law [
31]. The mineralogical composition of chalcedony can be investigated by means of X-ray diffraction, which is a micro destructive analytical technique, and/or Raman spectroscopy, with the latter being most effective and not destructive [
32].
The XRD patterns of the two types of aquaprase (
AQ_type I and
AQ_type II) are very similar and characterized by peaks ascribable to silica polymorphs, where quartz is the main phase and is associated with moganite in minor amounts. In
Figure 4a, the pattern of an
AQ-type I is reported; in
Figure 4b, the main signals of quartz and moganite are shown more in detail. The strongest peaks located at 20.9 and 26.7 2θ(°) correspond to diffraction from the (100) and (101) Bragg planes of α-quartz, respectively, accompanied by all the expected minor reflections (ICSD 15-6196). On the contrary, the presence of moganite is often masked by the diffraction pattern of quartz as a result of their high structural similarity [
33,
34]. However, characteristic signals from moganite can be found by looking carefully at the diffraction pattern in the range of 18–32 2θ(°) [
32,
35]. Indeed, we register moganite reflections as minor contributions in this region. Shoulders at 19.9°, 25.9°, and 28.9 2θ(°) are ascribable to diffraction from the (110), (−121), and (−112) diffraction planes of moganite, respectively (ICSD 67-6669). Moreover, the mineralogical composition of the white and dark areas associated with aquaprase is always quartz and moganite, indicating that these areas are also chalcedony.
Raman spectra of the aquaprase chalcedony samples confirm the presence of the two silica polymorphs, quartz and moganite (
Figure 5), which were highlighted by employing the X-ray powder diffraction [
36,
37]. Raman spectroscopy is, in fact, a more suitable technique than X-ray diffraction for distinguishing moganite and α-quartz. It is indeed possible, despite the overlapping of some of the signals of these two polymorphs [
38], to clearly distinguish them based on their main signals at 465 cm
−1 for α-quartz and 501 cm
−1 for moganite, respectively. These two signals represent the main vibration of the Si–O–Si bond. The position of this band, at slightly higher frequencies in the moganite than in the α-quartz, reflects a different mode of vibration due to the difference in symmetry of the lattice, which, as mentioned above, is monoclinic in the moganite and trigonal in the α-quartz. In the case of aquaprase, the presence of the two polymorphs was revealed in both the
AQ_type I and
AQ_type II subcategories. In
Figure 5, we can see the spectrum of an
AQ_type I sample in which the contribution of α-quartz at 465 cm
−1, corresponding to the symmetric bend of SiO
4 tetrahedra [
39,
40,
41] and the characteristic peak of moganite at 501 cm
−1 are reported.
Importantly, neither XRD nor Raman analyses registered the presence of additional phases other than quartz and moganite in our aquaprase samples (see
Figure 3 and
Figure 4 again).
3.4. Microstrctural Analysis
The
AQ_type I and
AQ_type II samples are very similar to each other from a microscopical point of view, exhibiting a very complex microstructure. In particular, the bluish green and turquoise cloudy zones visible to the naked eye are dominated, at the microscopical scale, by the presence of cryptocrystalline quartz (areas A in
Figure 6a,b), whose crystals are not distinguishable and look like a compact and uniform mass, given their size and their isotropic behavior, and are common in cryptocrystalline SiO
2 varieties. On the contrary, in the white areas of the aquaprase samples, microcrystalline quartz crystals, having different orders of magnitude, are found interspersed locally (areas B in
Figure 6a,b). In
AQ_type II samples, in the white areas, there are also feathery arrangements of crystals (typical feature of chalcedony) present (area B in the
Figure 6b). Well-developed bands of fibrous quartz are observable also between the bluish green/turquoise and white areas of the
AQ_type II samples (area C in
Figure 6b).
SEM analyses were carried out with the aim of specifically investigating the colored areas of the aquaprase in order to highlight the presence of possible inclusions causing the coloring of this gemological variety. The BSE images of the this areas of the aquaprase samples are characterized by a background mass with high gray scale values, in which the presence of irregular darker branched and spherical bodies is evident (
Figure 7a,b). The colored areas exhibit a similar chemical composition to the white areas, mainly SiO
2. No evidence of any inclusions containing chromium was observed, even though we cannot exclude their presence, potentially with a grain size of below the SEM resolution (inclusions smaller than 100 nm as reported by [
19]).
3.5. Chemical Analysis
The results of several points’ analysis carried out by means of the LA–ICP–MS technique are reported in
Table 2. The analysis was carried out in different areas of the aquaprase samples and, specifically, in the bluish green areas of
AQ_type I, in the turquoise areas of
AQ_type II aquaprase, as well as in the white and brown areas of the
AQ_type I.
The aquaprase samples here analyzed are characterized by high contents of Mg (around 4000–7500 ppm) and Al (3000–6000 ppm), which show a positive correlation between them. Traces of Ca, K, and Na are also detected.
Among the chromophore ions, Cr is the most abundant in the bluish green and turquoise areas, with an average content of 1446 and 1194 ppm, respectively. Cr
3+ could be related to nano inclusions (smaller than 100 nm) [
19,
42], or it could be interstitial in the quartz structure [
17]. Iron can be structurally incorporated into quartz by substituting Si
4+ or at interstitial sites, although in the case of aquaprase, it is reasonable that the significant contents of this element are rather related to the presence of micro inclusions of Fe-containing minerals or compounds [
43,
44]. In fact, Fe concentrations are particularly high in the brown areas of aquaprase samples, whereas in the bluish green and turquoise areas of the
AQ_type I and
AQ_type II aquaprase, they are lower and uneven. The Ni
2+ ions could reside in some nano inclusions not detected in the SEM analyses, or it could be in the quartz structure in the tetrahedral interstitial sites, according to [
42]. The Cr content had a positive correlation with the contents of Al, Mg, and Ni, but we cannot speculate about any possible inclusions.
As expected, the white area of the AQ_type I samples did not show significant contents of chromium but only traces of titanium (895 ppm) and iron (152 ppm) as chromophore ions. Among the alkaline and earth alkaline elements, K is the most abundant (2467 ppm), followed by Ca (2008 ppm) and Na (860 ppm). Mg and Al, very abundant in the bluish areas, are here measured as a few hundreds of ppm instead of thousands of ppm. Na+ and K+ ions commonly occur as extra-framework elements within the quartz structure, where they function to balance the charge of trivalent substituent ions, such as Al3+. These alkali ions are also frequently associated with distinctive mineral micro inclusions embedded within the quartz matrix. The high concentrations of Al and Mg, as well as their positive correlation, further suggest that these elements may be contributed by mineral inclusions, potentially including phyllosilicates.
The brown areas of aquaprase chalcedony are characterized by a high content of Fe (average 1976 ppm), which can be responsible for the brown color. Moreover, Al, Na, and Mg showed concentrations that were more than halved compared to those of the bluish green and turquoise areas. We also found a significant amount of K and Ca and a higher content of Ti with respect to the bluish green and turquoise areas (average 773 ppm).
It is very interesting to note that the aquaprase samples contained U, although in a very low concentration (about 1 ppm). Uranium can be found as trace elements in agate, chalcedony, and opal around the world [
28]. Its presence is primarily associated with the transport of chemical elements during late-stage volcanic and post-volcanic alteration processes, leading to their accumulation during chalcedony formation. Consequently, the high concentrations of U may provide significant insights into the formation environment of aquaprase. However, these implications remain speculative due to the lack of knowledge of the specific location of aquaprase deposit. This element, in the form of uranyl ions, is considered the cause of the greenish luminescence of various gems belonging to the silica groups [
27,
28,
45]. The bright green fluorescence to short-wave radiation we observed in correspondence to the white areas of our samples is due to the uranyl ions. Although the concentration of uranium in our samples is very low, the uranyl is a very effective luminescence activator, and successful excitation is also possible with uranium content at the sub-ppm level [
27,
28]. The lack of luminescence in the brown and bluish green/turquoise areas of the samples containing similar amounts of uranium is related to the occurrence of a higher content of iron, a quencher of the uranyl luminescence [
28,
46].
4. Conclusions
Aquaprase™ chalcedony is currently a popular choice in fashion, often incorporated into stunning jewelry pieces. X-ray powder diffraction and Raman spectroscopy reveal that aquaprase consists predominantly of alpha-quartz with a minor amount of moganite. When viewed under reflected light, it exhibits attractive shades of blue and green, with some samples shifting toward a more green or “turquoise” hue. The color distribution in some samples is very homogeneous, while in others, aquaprase is accompanied by white and/or brown chalcedony in bands or spots, creating unique and intricate patterns.
Among the chromophore ions present, chromium is the most abundant, likely occurring as nanometric inclusions, followed by iron and nickel. Due to the significant contribution of chromium compared to other chromophores, it is considered the primary cause of the green coloration, classifying aquaprase within the chrome chalcedony group. The blue component of the color is attributed to light scattering. In aquaprase type II, the resulting “turquoise” color is a combination of chromium absorption and light scattering.
Aquaprase™ can be easily distinguished from the “apple” green chrysoprase variety, which is the most similar in color among the chalcedony varieties, by its main coloring agent—chromium in aquaprase versus nickel in chrysoprase.
Author Contributions
Conceptualization, S.M., N.M. and I.A.; sampling, Y.M.; formal analysis, S.M., N.M., V.D. and I.A.; writing—original draft preparation, S.M., N.M. and I.A.; writing—review and editing, S.M., N.M., I.A. and L.P.; supervision, N.M. All authors have read and agreed to the published version of the manuscript.
Funding
This research received no external funding.
Data Availability Statement
Additional details on the data reported in this manuscript can be obtained by the authors upon request.
Acknowledgments
The authors thank Avant Chordia of Guman Impex Pvt Ltd. for providing the samples investigated here. Funding for this research was provided by the Italian Ministry of Education (MIUR) (PRIN2017–Mineral Reactivity, A Key to Understand Large-Scale Processes: Award No. 2017 L83S77) and “Dipartimenti di Eccellenza 2023-2027“.
Conflicts of Interest
Yianni Melas is employed by the company GEMEXPLORER Ltd. The remaining authors declare that the research was conducted in the absence of any commercial or financial relationships that could be construed as a potential conflict of interest.
References
- O’Donoghue, M. Gems—Their Sources, Description and Identification, 6th ed.; Butterworth-Heinemann: Oxford, UK, 2006; pp. 307–308. [Google Scholar]
- Gliozzo, E. Variations on the silica theme: Classification and provenance from Pliny to current supplies. EMU Notes Mineral. 2019, 20, 13–85. [Google Scholar]
- Wu, J.; Ma, H.; Ma, Y.; Ning, P.; Tang, N.; Li, H. Comparison of Natural and Dyed Fire Opal. Crystals 2022, 12, 322. [Google Scholar] [CrossRef]
- Webster, R. Gems—Their Sources, Description and Identification, 5th ed.; Heinemann: Oxford, UK, 2006. [Google Scholar]
- Shigley, J.E.; Laurs, B.M.; Renfro, N.D. Chrysoprase and prase opal from Haneti, Central Tanzania. Gems Gemol. 2009, 45, 271–279. [Google Scholar] [CrossRef]
- Barsanov, G.P.; Jakovleva, M.E. Mineralogical investigations of some precious and semiprecious varieties of cryptocrystalline silica. Novye Danye Miner. 1981, 29, 5–35. (In Russian) [Google Scholar]
- Heflik, W.; Kwiecinska, B.; Natkaniec-Nowak, L. Colour of chrysoprase in light of mineralogical studies. Aust. Gemmol. 1989, 17, 43–46, 58–59. [Google Scholar]
- Graetsch, H.A. Microstructure and origin of colour of chrysoprase from Haneti (Tanzania). Neues Jahrb. Mineral. 2011, 188, 111–117. [Google Scholar] [CrossRef]
- Eggleton, R.A.; Gerald, J.F.; Foster, L. Chrysoprase from Gumigil, Queensland. Aust. J. Earth Sci. 2011, 58, 767–776. [Google Scholar] [CrossRef]
- Caucia, F.; Marinoni, L.; Ghisoli, C.; Leone, A. Gemological, physical and chemical properties of prase opals from Hanety Hill (Tanzania). Period. Mineral. 2016, 85, 41–50. [Google Scholar]
- Monico, S.; Cantaluppi, M.; Diella, V.; Gatta, D.G.; Adamo, I.; Fumagalli, P.; Marinoni, N. Similarities and differences among selected varieties of chalcedony: Chemistry, mineralogy and microstructure. Mineral. Mag. 2024, 88, 136–146. [Google Scholar] [CrossRef]
- Sachanbiński, M.; Janeczeck, J.; Platonov, A.; Rietmeijer, F.J.M. The origin of colour of chrysoprase from Szklary (Poland) and Sarykul Boldy (Kazakhstan). Neues Jahrb. Mineral. Abh. 2011, 177, 61–76. [Google Scholar] [CrossRef]
- Čermáková, Z.; Hradil, D.; Bezdička, P.; Hradilová, J. New data on kerolite-pimelite series and the colouring agent of Szklary chrysoprase, Poland. Phys. Chem. Miner. 2017, 44, 193–202. [Google Scholar] [CrossRef]
- Jiang, Y.; Guo, Y. Genesis and influencing factors of the colour of chrysoprase. Sci. Rep. 2021, 11, 9939. [Google Scholar] [CrossRef] [PubMed]
- Nagase, T.; Akizuki, M.; Onoda, M.; Sato, M. Chrysoprase from Warranda, Western Australia. Neues. Jahrb. Mineral. 1997, 7, 289–300. [Google Scholar] [CrossRef]
- Hatipoğlu, M.; Ören, U.; Kibici, Y. Micro-Raman spectroscopy of gem-quality chrysoprase from the Biga-Çanakkale region of Turkey. J. Afr. Earth Sci. 2011, 61, 273–285. [Google Scholar] [CrossRef]
- Philip, G.; Brown, G. Mtorolite. Aust. Gemmol. 1990, 17, 205–207. [Google Scholar]
- Hyršl, J.; Petrov, A. Gemstones and ornamental stones from Bolivia: A review. J. Gemmol. 1998, 26, 41–47. [Google Scholar] [CrossRef]
- Hyršl, J. Chrome-chalcedony—A review. J. Gemmol. 1999, 26, 364–370. [Google Scholar] [CrossRef]
- Willing, M.J.; Stocklmayer, S.M. A new chrome chalcedony occurrence from Western Australia. J. Gemmol. 2003, 28, 265–279. [Google Scholar] [CrossRef]
- Ye, M.; Shen, A.H. Gemmological and mineralogical characteristics of chrysocolla chalcedony from Taiwan, Indonesia and the USA, and their separation. J. Gemmol. 2020, 37, 262–280. [Google Scholar] [CrossRef]
- Laurs, B.M. Chrysocolla chalcedony from Spain. J. Gemmol. 2015, 34, 472. [Google Scholar]
- Laurs, B.M.; Renfro, N.D. Chrysocolla chalcedony with native copper inclusions. J. Gemmol. 2018, 36, 92. [Google Scholar]
- Renfro, N. A new natural-color bluish green chalcedony. Gems Gemol. 2015, 51, 452–454. [Google Scholar]
- Available online: https://www.aquaprase.com (accessed on 28 October 2024).
- Fritsch, E.; Rossman, G.R. Un update on color in gems. Part 3: Color caused by band gaps and physical phenomena. Gems Gemol. 1988, 24, 81–102. [Google Scholar] [CrossRef]
- Gaillou, E.; Delaunay, A.; Rondeau, B.; Bounhnik-le-Coz, M.; Fritsch, E.; Cornen, G.; Monnier, C. The geochemistry of gem opals as evidence of their origin. Ore Geol. Rev. 2008, 34, 113–116. [Google Scholar] [CrossRef]
- Götze, J.; Gaft, M.; Mötze, R. Uranium and uranyl luminescence in agate/chalcedony. Mineral. Mag. 2015, 79, 983–993. [Google Scholar] [CrossRef]
- Heaney, P.J.; Post, J.E. The widespread distribution of a novel silica polymorph in microcrystalline quartz varieties. Science 1992, 255, 441–443. [Google Scholar] [CrossRef]
- Heaney, P.J.; Mckeown, D.A.; Post, D.J. Anomalous behavior at the I2/a to Imab phase transition of moganite: An analysis using hard-mode Raman spectroscopy. Am. Mineral. 2007, 92, 631–639. [Google Scholar] [CrossRef]
- Miehe, G.; Graetsch, H. Crystal structure of moganite: A new structure type of silica. Eur. J. Miner. 1992, 4, 693–706. [Google Scholar] [CrossRef]
- Rodgers, K.; Cressey, G. The occurrence, detection and significance of moganite (SiO2) among some silica sinters. Miner. Mag. 2021, 65, 157–167. [Google Scholar] [CrossRef]
- Graetsch, H.; Flörke, O.; Miehe, G. Structural defects in microcrystalline silica. Phys. Chem. Miner. 1987, 14, 249–257. [Google Scholar] [CrossRef]
- Smith, D.K. Opal, cristobalite, and tridymite: Noncrystallinity versus crystallinity, nomenclature of the silica minerals and bibliography. Powder Diffr. 1998, 13, 2–19. [Google Scholar] [CrossRef]
- Lee, S.; Xu, H.; Xu, H.; Neuefeind, J. Crystal Structure of Moganite and Its Anisotropic Atomic Displacement Parameters Determined by Synchrotron X-ray Diffraction and X-Ray/Neutron Pair Distribution Function Analyses. Minerals 2021, 11, 272. [Google Scholar] [CrossRef]
- Schmidt, P.; Bellot-Gurlet, L.; Léa, V.; Sciau, P. Moganite detection in silica rocks using Raman and infrared spectroscopy. Eur. J. Miner. 2013, 25, 797–805. [Google Scholar] [CrossRef]
- Ilieva, A.; Mihailova, B.; Tsintsov, Z.; Petrov, O. Structural state of microcrystalline opals: A Raman spectroscopic study. Am. Mineral. 2007, 92, 1325–1333. [Google Scholar] [CrossRef]
- Kingma, K.J.; Hemley, R.J. Raman spectroscopic study of microcrystalline silica. Am. Mineral. 1994, 79, 269–273. [Google Scholar]
- Masso, J.D.; She, C.; Edwards, D.F. Effects of inherent electric and anisotropic forces on Raman spectra in α-quartz. Phys. Rev. B 1980, 1, 4179. [Google Scholar] [CrossRef]
- McMillan, P.F.; Hess, A.C. Ab initio valence force field calculations for quartz. Phys. Chem. Miner. 1980, 17, 97–107. [Google Scholar] [CrossRef]
- Umari, P.; Pasquarello, A.; Dal Corso, A. Raman scattering intensities in α-quartz: A first-principles investigation. Phys. Rev. B 2001, 63, 094305. [Google Scholar] [CrossRef]
- Solntsev, V.P.; Mashkovtsev, R.I.; Shcherbakova, M.Y. Centers of copper and nickel in alpha-quartz. Solid State Phys. 1974, 16, 1824–1825. (In Russian) [Google Scholar]
- Götze, J.; Pan, Y.; Müller, A. Mineralogy and mineral chemistry of quartz: A review. Mineral. Mag. 2021, 85, 639–664. [Google Scholar] [CrossRef]
- Lv, H.; Guo, Y. Genesis of the Body Color of Brazilian Gem-Quality Yellow-Green Opal. Crystals 2023, 13, 316. [Google Scholar] [CrossRef]
- Götze, J.; Stanek, K.; Orozco, G.; Liesegang, M.; Mohr-Westheide, T. Occurrence and distribution of moganite and opal-CT in agates from Paleocene/Eocene tuffs, El Picado (Cuba). Minerals 2021, 11, 531. [Google Scholar] [CrossRef]
- Marfunin, A.S. Spectroscopy, Luminescence and Radiation Centres in Minerals; Springer: Berlin/Heidelberg, Germany; New York, NY, USA, 1979; p. 352. [Google Scholar]
| Disclaimer/Publisher’s Note: The statements, opinions and data contained in all publications are solely those of the individual author(s) and contributor(s) and not of MDPI and/or the editor(s). MDPI and/or the editor(s) disclaim responsibility for any injury to people or property resulting from any ideas, methods, instructions or products referred to in the content. |
© 2024 by the authors. Licensee MDPI, Basel, Switzerland. This article is an open access article distributed under the terms and conditions of the Creative Commons Attribution (CC BY) license (https://creativecommons.org/licenses/by/4.0/).